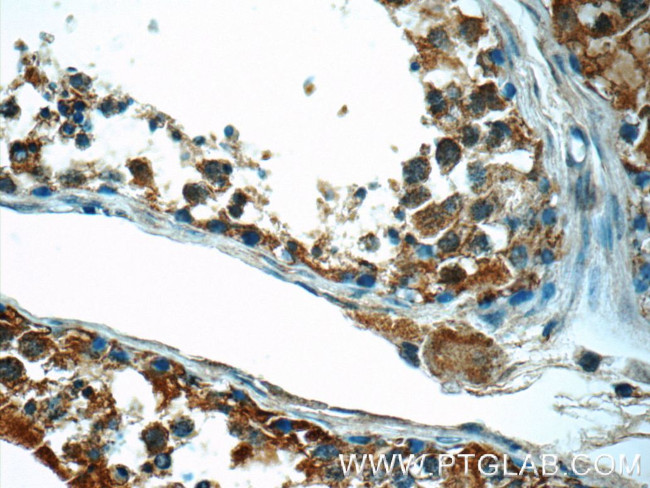
CEP55 Antibody in Immunohistochemistry (Paraffin) (IHC (P))
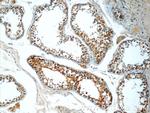
CEP55 Antibody in Immunohistochemistry (Paraffin) (IHC (P))

Search
Proteintech
CEP55 Polyclonal Antibody
{{$productOrderCtrl.translations['antibody.pdp.commerceCard.promotion.promotions']}}
{{$productOrderCtrl.translations['antibody.pdp.commerceCard.promotion.viewpromo']}}
{{$productOrderCtrl.translations['antibody.pdp.commerceCard.promotion.promocode']}}: {{promo.promoCode}} {{promo.promoTitle}} {{promo.promoDescription}}. {{$productOrderCtrl.translations['antibody.pdp.commerceCard.promotion.learnmore']}}
产品信息
23891-1-AP
种属反应
已发表种属
宿主/亚型
分类
类型
抗原
偶联物
形式
浓度
规格
纯化类型
保存液
内含物
保存条件
运输条件
产品详细信息
Immunogen sequence: MSSRSTKDL IKSKWGSKPS NSKSETTLEK LKGEIAHLKT SVDEITSGKG KLTDKERHRL LEKIRVLEAE KEKNAYQLTE KDKEIQRLRD QLKARYSTTA LLEQLEETTR EGERREQVLK ALSEEKDVLK QQLSAATSRI AELESKTNTL RLSQTVAPNC FNSSINNIHE MEIQLKDALE KNQQWLVYDQ QREVYVKGLL AKIFELEKKT ETAAHSLPQQ TKKPESEGYL QEEKQKCYND LLASAKKDLE VERQTITQLS FELSEFRRKY EETQKEVHNL NQLLYSQRRA DVQHLEDDRH KTEKIQKLRE ENDIARGKLE EEKKRSEELL SQVQFLYTSL LKQQEEQTRV ALLEQQ (1-355 aa encoded by B C008947)
靶标信息
Plays a role in mitotic exit and cytokinesis (PubMed:16198290, PubMed:17853893). Recruits PDCD6IP and TSG101 to midbody during cytokinesis. Required for successful completion of cytokinesis (PubMed:17853893). Not required for microtubule nucleation (PubMed:16198290). Plays a role in the development of the brain and kidney (PubMed:28264986). [UniProt]
仅用于科研。不用于诊断过程。未经明确授权不得转售。
生物信息学
蛋白别名: cancer/testis antigen 111; centrosomal protein 55kDa; Centrosomal protein of 55 kDa; CEP55; unnamed protein product; Up-regulated in colon cancer 6
基因别名: 1200008O12Rik; 2700032M20Rik; C10orf3; CEP55; CT111; MARCH; RGD1305340; URCC6
UniProt ID: (Human) Q53EZ4, (Mouse) Q8BT07, (Rat) Q4V7C8
Entrez Gene ID: (Human) 55165, (Mouse) 74107, (Rat) 294074